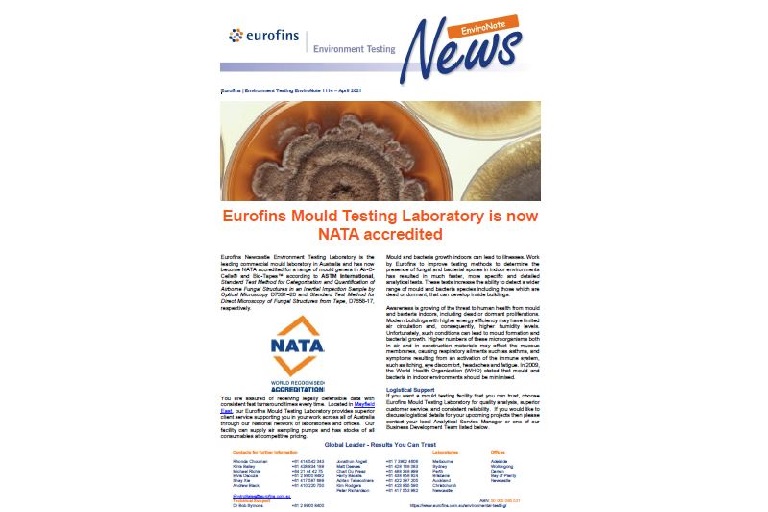
NATA Mould Lab

Eurofins EnviroNote News
Search >>
Welcome to the Eurofins Environment Testing e-newsletter. EnviroNote News aims to regularly deliver the latest technology, testing, staff and company updates as well as industry information to our clients and associates across Australia and New Zealand.
Ensure you're always up to date - subscribe to EnviroNotes.